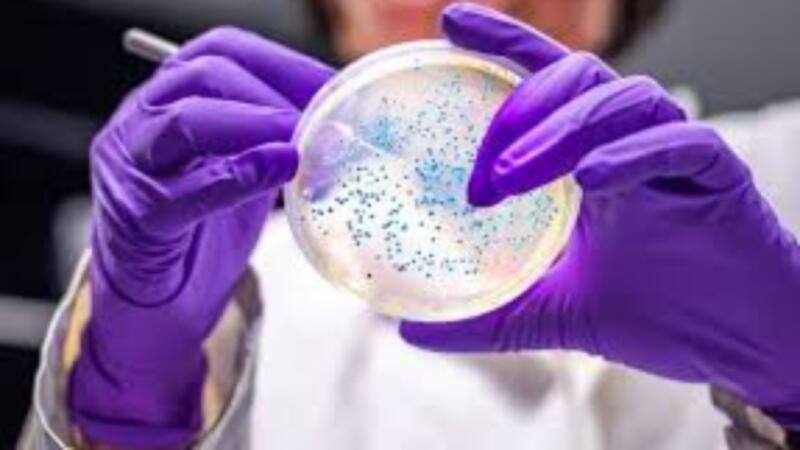

CES 2025 Apresenta Tendências Tecnológicas que Definirão o Futuro
Feira em Las Vegas destaca avanços em inteligência artificial, saúde digital e computação quântica.
SCI-TECH

Comentários
Comentário enviado com sucesso!